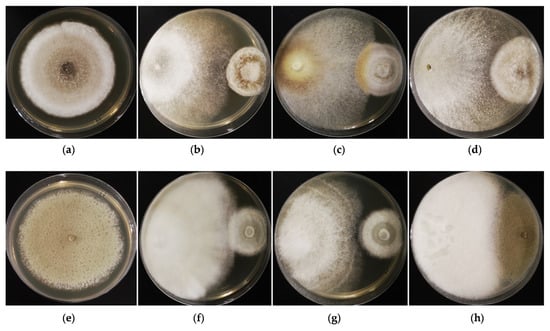

Abstract
There has been renewed interest in the application of endophytic fungi to control phytopathogenic fungi, which cause significant damage to crop health, ultimately leading to losses in agricultural productivity. Endophytic fungi inhibit pathogens via different modes of action—mycoparasitism, competition (for nutrients and ecological niches), antibiosis, and induction of plant defense—thus demonstrating the ability to control a wide range of phytopathogenic fungi in different growth phases and habitats. However, many studies have been conducted under laboratory conditions, and there is a huge lack of studies in which real field testing was performed. Aspergillus, Clonostachys, Coniothyrium, Trichoderma, and Verticillium have been proven to be the most effective fungal biocontrol agents. Trichoderma is regarded as the most promising group in commercial formulations. In this study, we attempted to emphasize the significance of fungal endophytes in controlling phytopathogenic fungi, while reporting recent advances in endophytic biology and application.
1. Introduction
1.1. Phytopathogenic Fungi and Their Significance
The exponential growth of the human population is one of the major problems facing today’s world. More than 7.884 billion people are alive today [1], and it is predicted that the population will reach 9.2 billion by 2050 [2]. Feeding this growing population is becoming a huge problem, putting enormous pressure on various agricultural production systems. Land expansions for agriculture may not be always possible, although increasing the production per hectare and reducing harvest losses due to various biotic and abiotic factors would be ideal [3]. In this regard, the key roles of pests are significant, since according to the Food and Agriculture Organization of the United Nations (FAO) [4], plant diseases are responsible for about USD 220 billion in annual losses to the world economy. Plant diseases result in the loss of 10–42% of the world’s major crops [5]. Of these diseases, 70–80% are caused by pathogenic fungi [6]. Several fungal epidemics have been reported throughout the history of agriculture. The coffee rust epidemic in the 1870s due to Hemileia vastatrix caused a huge drop in the harvest in eastern Africa and Ceylon (now Sri Lanka). At the time, Ceylon was the leading coffee exporting country in the world; however, coffee production fell from 45 million kg in 1870 to 2.5 million in 1889. This island nation could not recover its production, and tea plantations replaced the majority of the coffee producing land. This scenario brings changes in the beverage habits of British people, from coffee to tea [7]. In 1943, the Great Bengal Famine, particularly due to the brown spot disease in rice caused by the Cochliobolus miyabeanus (formerly known as Helminthosporium oryzae, current name Bipolaris oryzae), led to the death of nearly three million people, who suffered from severe hunger owing to the yield reductions of their staple food, rice, by up to 92% [8]. While the southern corn leaf blight epidemic in 1970 caused by Cochliobolus heterostrophus (also known as Bipolaris maydis, previously Helminthosporium maydis) caused corn losses of up to 50% in the USA [9]. At present, Blumeria graminis, Botrytis cinerea, Colletotrichum spp., Fusarium graminearum, F. oxysporum, Magnaporthe oryzae, Melampsora lini, Mycosphaerella graminicola, Puccinia spp., and Ustilago maydis are the top ten fungi groups based on the scientific/economic importance and possess great potential to emerge as devastating disease-causing agents [10]. Most fungal plant pathogens belong to the phyla Ascomycota and Basidiomycota. Fungal plant pathogens can be classified into several classes among Ascomycota, such as the Dothideomycetes (e.g., Cladosporium spp.), Sordariomycetes (e.g., Magnaporthe spp.), and the Leotiomycetes (e.g., Botrytis spp.). Rusts (Pucciniomycetes) and smuts (spread among the subphylum of Ustilaginomycotina), the two major plant pathogen groups, belong to the Basidiomycota [11]. These fungi can cause damage to plants as well. Upon infection, phytopathogenic fungi interfere with plant metabolism and affect their normal/regular functions (and hence diseases) by producing enzymes, toxins, and other metabolic inhibitors such as hormones or absorbing nutrients from the host plants by growing internally or externally to the plant host [6,12]. Plants switch to active defense mechanisms to counteract the virulence factors of the fungi, while fungi may not resist or die; in contrast, if plants succumb to the virulence of the fungi, plants get sick, and the fungi become phytopathogenic [13,14].
1.2. Endophytic Fungi and Their Benefits
The term endophyte was first coined by De Bary in 1866. He referred to any organism that grows within plant tissues as an endophyte. Endophytes are generally not considered pathogens, and they often form a symbiotic relationship with plant hosts without causing any immediate adverse effects or disease symptoms [15,16,17]. Those endophytes that do not cause diseases in plants are called true endophytes, while others cause diseases in plants at some stage of their lifecycle due to various reasons, such as the weakening of the plant, environmental changes, and the type of host. For example, Fusarium species are found as harmless (latent) endophytes in carrots, though they cause head blight disease in cereals. Similarly, Ramularia collo-cygni, which causes necrotic disease in barley, can be found as a harmless endophyte in many other cereals [18].
Based on their phylogeny and life cycle characteristics, endophytic fungi have been divided into two major groups: clavicipitaceous (infecting some grasses limited to cool regions) and non-clavicipitaceous endophytes (from asymptomatic tissues of non-vascular plants, ferns and allies, conifers and angiosperms, also restricted to the Ascomycota or Basidiomycota) [19]. They have coexisted with plants for over 400 million years [20]. Today, over 300,000 plant species have been identified, and it is believed that each of them harbors at least one endophyte [21]. They propagate horizontally or vertically, thus increasing their survivability [22,23]. They have also been extensively examined in a range of geographic and climatic regions that are home to many ecological habitats from xeric to arctic, temperate to tropical forests, grasslands to croplands, and savannahs [24].
The benefits of endophytes to their host plants are significant; in their review, Baron and Rigobelo [25] described the advantageous role of endophytic fungi in depth. Endophytic fungi give direct benefits to their plant host (through mutualistic symbiosis interactions) by enhancing nutrient acquisition (e.g., N, P, K, Mg, and other macro and micronutrients), siderophore production, phytohormone productions for plant growth and development (e.g., auxins, cytokinins, gibberellin), and increasing the photosynthetic activity of the plant. They also offer many indirect effects such as an increase in secondary metabolites (e.g., alkaloids, steroids, terpenoids), improve protection against abiotic stresses (e.g., drought, heavy metal, salinity, temperature), biotic stresses (e.g., microbial pathogens, herbivores animals, and other insect pests), and trigger plant active defense mechanisms. The collective effect of a few or more of them thereby supports improvements in the fitness of the plant and also promotes plant growth and physiology, making the host plant robust, and leading to the inhibition of phytopathogens [26].
Today, the potential to use endophytes as a valuable source of novel products for utilization in agriculture, medicine, and other industries has been well identified [27]. The pharmacological properties of major bioactive compounds synthesized by endophytic fungi have been recognized; for example, Stierle and co-workers [28] identified that Taxomyces andreanae (associated with Taxus brevifolia) has the ability to synthesize taxol, which has an antitumor effect against breast and ovarian cancers. Many other anti-cancer drugs have been isolated, such as Asperfumoid (from Aspergilus fumigatus), Aspernigerin (from Aspergillus niger), and Camptothecin (from Fusarium solani, Entrophospora infrequens, Neurospora sp., Nodulisiporium sp.) [29]. Antidiabetic, antifungal, antimalaria/antiparasite, antimicrobial, antioxidants, antiviral and immunosuppressive properties of endophytic fungi have also been identified [30]. The utilization of endophytic fungi in agriculture as biofertilizers [31] and biocontrol of pests [32] has been well documented in recent years. Endophytic fungi are also recognized as a potential source of industrial enzyme producers, including in the food and biofuel industries [33].
In this review, we attempted to discuss the application of endophytic fungi to control phytopathogenic fungi. First, we discussed the current requirements of endophytes as biocontrol agents. Second, we stressed some basics of endophytic fungi in order to better understand their biocontrol ability, along with successful studies in this respect. Finally, the mode of action of endophytic fungi in controlling phytopathogenic fungi is described.
2. Urgent Need for Biocontrol Agents
The application of pesticides is the most common practice in agriculture, due to their improved productivity and reduced yield losses via efficient control of pathogens (including during disease outbreaks), ease of application/handling and minimal requirements in terms of labor cost, and so on. These advantages have not been acknowledged by many in the research community, however, due to their undeniable disadvantages, which include water, soil, and air pollution, impact on soil fertility and non-target organisms, and health risks to humans and their animals [34,35]. Because of these negative consequences, numerous chemicals have been banned worldwide. An example is methyl bromide (MeBr), a broad-spectrum soil fumigant. It was mainly applied to control soil-borne pathogens; however, due to its ozone-depleting nature, it was completely banned in 2005, with a few exceptions [36]. The development of efficient synthetic chemicals, while addressing the aforesaid negatives, remains a huge challenge for the pesticide industry, which has been struggling to improve its products and produce novel pesticides [37]. Public and governments of many countries are pushing for pesticide-free farming, aiming to find alternative approaches to control phytopathogens [38,39]. In this scenario, traditionally, many environmentally friendly approaches, including mixed cropping, crop rotation, resistant cultivars/selective breeding, application of biocontrol agents, flooding, solarization, steaming, pasteurization, hot water treatment, and bio-fumigation have been used to control the pathogens. The effectiveness of controlling pathogens is questionable, and they also have their own advantages and disadvantages. For example, today, the utilization of resistant cultivars has come to be of interest owing to the advancement of molecular techniques [40], although with the broad range of pathogens and the rise of virulent strains/populations of pathogens, it is difficult to improve the resistant cultivars and non-host-specific crops [41,42]. Nonetheless, among the aforementioned methods, the application of biocontrol agents has become one of the ongoing trends in the field, as it presents promising alternatives for the protection of plants [43]. For instance, due to the banning of MeBr, the only feasible method for eradicating the devastating Fusarium diseases in the field is to use resistant cultivars or rootstocks. Recent studies have shown the importance of the application of endophytic fungi in the biocontrol of Fusarium diseases [44,45].
Substantial technological, economic, and political discussion has been sparked by the idea of biocontrol with the goal of fostering sustainable agriculture at a lower environmental cost. Some countries have adopted protective strategies that can reduce pesticide usage by about 50% [46]. It is important to understand the meaning of the concept of biological control. Traditionally, biological control has been defined as using an organism (not human or plant) to control or decrease the population of a pathogen or disease [47]. In contrast, biological control is an attempt to translate a phenomenon that is common in nature to agricultural systems, taking advantage of natural and established relationships [48]. Biological control agents (most, but not all) have demonstrated the ability to interact with and/or colonize plants, and they are able to develop complex inter-kingdom communication in which signaling occurs through a biochemical language with plants [49,50]. To disrupt the life cycle of pathogens, biocontrol agents use different antagonistic mechanisms [51]; such effects lead to infection prevention and reduced colonization of host plant tissues, and reduced sporulation, ultimately affecting the pathogen’s ability to survive [52,53]. Biocontrol agents enhance plant immunity by increasing the expression of defense-related genes and systemic resistance [48]. Fungi and bacteria are considered the most prominent agents for controlling plant pathogens. One of the most exciting groups that can be used in biological control is endophytic fungi [42]. It is also worth mentioning that endophytic fungi, once associated with plants, provide protection to the host plant throughout their entire life cycle. Endophytic fungi may endure various adverse conditions while continuing to benefit the plant [54]. The other important thing to consider is that endophytic fungi do not develop pathogen-resistant strains like synthetic fungicides do [52]. These characteristics have led researchers to use them as biocontrol agents for directing sustainable agriculture practices.
3. Endophytic Fungi as Successful Biocontrol Agents
3.1. Emergence of Endophytic Fungi as Biocontrol Agents
In 1914, Carl Freiherr von Tubeuf introduced the biological control of fungi plant diseases for the first time [55]. Despite their advantage in terms of environmentally friendly utilization, many other characteristics make them competitive for usage with other disease control strategies. The ability to colonize plant tissues makes them better biological control agents for surviving dangerous UV rays, temperature fluctuations, and continued availability against pathogens [56]. Along with the previously mentioned merited features, the biological control ability of phytopathogen began to emerge in the 1930s. Weindling [57] proved that Trichoderma lignorum protected citrus seedlings against the Rhizoctonia solani. Sutton et al. [58] acknowledged the use of Gliocladium roseum, as it consistently ranked high among other organisms with exceptional effectiveness against Botrytis cinerea in a variety of greenhouse-grown flowers and vegetables, including begonia (Begonia sp.), cucumber (Cucumis sativus), cyclamen (Cyclamen sp.), Exacum affine, geranium (Geranium sp.), pepper (Piper nigrum), poinsettia (Euphorbia sp.), and tomato (Solanum lycopersicum). Here, it was found that G. roseum was as effective as or more effective than fungicide treatments on leaves, bracts, stems, flowers, and fruits in nearly all cases.
The way in which biotrophic and necrotrophic fungi are influenced is of interest. Biotrophic pathogens, such as those that cause rust and mildew disease, often have a brief epiphytic phase, and require little to no exogenous nutrients to penetrate. Mycoparasitism (rather than competitors) could be the most useful strategy for the biocontrol of the targeted fungi at this stage of the cycle. However, the collective effects of other modes of actions of endophytes (which are described later in this review) add much effectiveness to their abilities to control phytopathogens. Meanwhile, unspecialized necrotrophs, such as Alternaria sp., Botrytis sp., Cochliobolus sp., Phoma sp., and Septoria sp., typically grow saprophytically on the phylloplane and absorb external nutrients before they penetrate. In such a situation, antagonists behaving as nutrient competitors might be useful. In addition, there is a general consensus that biocontrol agents that act as nutrient competitors (and not through antibiosis) can only be used in a prophylactic manner [59]. Rajani et al. [60] found the ability of the same genera of endophytic fungi to control several species of pathogens. In this context, they found that three Trichoderma species, namely T. harzianum, T. longibrachiatum and T. pleuroti, were capable of completely inhibiting the mycelial growth of Sclerotinia sclerotiorum, Sclerotium rolfsii, and Fusarium oxysporum. Several endophytes from different genera can also be utilized to kill a single targeted fungal pathogen. For instance, the fungi Acremonium alternatum, Acrodontium crateriforme, and Gliocladium virens are able to parasitize the powdery mildew pathogen in Erysiphaceae [61].
3.2. In Vitro Assay for Recognition of the Antagonistic Ability of Endophytic Fungi
First, endophytic fungi should be isolated from the healthy plant part/s. Then, to remove the surface soil and appendages, repeated washing under tap water needs to be carried out. Selected plant materials should be further cut into appropriately sized pieces (e.g., length, 1–2 cm for leaves; 5–7 cm for roots) and subjected to proper surface sterilization to remove epiphytic microbes from the plant tissues while keeping only the true endophytes [62]. Earlier in the 1990s, Schulz et al. [63] recommended several methods of surface sterilization, of these, ethanol, formaldehyde, and diluted sodium hypochlorite-based methods are still common practices in laboratories. Pilot studies can be used to determine the required sterilant solution, concentration, and exposure time [64]. Sterilants ought to be powerful enough to sterilize the plants’ surface without causing any damage to their tissues. The age, sensitivity, and tissue thickness of the selected plant parts should therefore be taken into account [65].
To investigate potential biocontrol agents, it is essential to obtain pure endophytic fungal cultures. After surface sterilization, the plant materials should undergo further serial washings to remove the excess sterilants, trimmed/sliced (e.g., 0.5 cm × 0.5 cm), and transferred to the culture medium [66]. Endophytic fungi can be recovered using a variety of culture media protocols, although potato dextrose agar (PDA) is one of the most popular. Other commonly used media include Agar containing Murashige and Skoog (MS) vitamins and sucrose, Czapek medium, Hagem minimal medium, Luria–Bertani medium, malt extract agar, tryptone bovine extract Aagar, and tryptone soybean agar. A common characteristic among these media is a slightly acidic pH range of 5.8–6.0, which enhances fungal growth [67]. Cultures should also contain antibiotics (e.g., penicillin, streptomycin) to inhibit bacterial growth. In general, the cultures are kept inside the incubator, maintaining a temperature regime between 23 and 29 °C for 3–14 days, according to requirements [66,68,69]. At this point, the initial identification of endophytics can be carried out using microscopic examination; however, genomic analysis is the most ideal and necessary for precise identification and confirmation [70,71].
The antagonistic activity against phytopathogenic fungi can be tested using dual culture methods [72,73,74]. A small portion of mycelia (e.g., 6 mm plugs) picked from the isolated cultures needs to be kept in a separate PDA along with the isolated phytopathogenic fungi mycelia, a few centimeters apart from one another. Then, the cultures should be incubated, and after 8–10 days, radial growth needs to be recorded by measuring the mean colony diameter [75]. Figure 1 shows dual culture assays for several endophytic fungi isolated from the coffee hosts (Coffea arabica) with fungal pathogens.
Figure 1.
Screening of endophytic fungi for antagonistic activity against phytopathogenic fungi. (a) Pathogen Alternaria alternata (CGMCC 3.15535); (b) endophytic fungus Arthrinium sp. (left, KUMCC 21-0407) and Alternaria alternata (right); (c) endophytic fungus Hypoxylon sp. (left, KUMCC 21-0356) and Alternaria alternata (right); (d) endophytic fungus Daldinia sp. (left, KUMCC 21-0398) and Alternaria alternata (right); (e) pathogen Penicillium digitatum (CGMCC 3.15410); (f) endophytic fungus Nodulisporium sp. (left, KUMCC 21-0375) and Penicillium digitatum (right); (g) endophytic fungus Colletotrichum sp. (left, KUMCC 21-0351) and Penicillium digitatum (right); (h) endophytic fungus Colletotrichum sp. (left, KUMCC 21-0401) and Penicillium digitatum (right). The fungal cultures were grown on PDA at 28 °C. The photographs show the cultures on the 10th day. It shows that endophytes restrict the growth of pathogens by occupying space and minimizing their spread over time.
In addition to the dual culture method, the co-culture of more than two species is also popular among researchers. In this procedure, the endophyte is placed in the center of the culture media (PDA) and is surrounded by different phytopathogen plugs that are kept a few centimeters away [62,76]. As of today, many endophyte fungi have had their biocontrol ability identified through in vitro assays. Table 1 summarizes some of the recent findings related to endophyte fungi with their targeted pathogen for control.

Table 1.
Some endophytic fungi with biocontrol potential against phytopathogenic fungi.
3.3. Application of Endophytic Fungi in Real Fields
Aspergillus, Clonostachys, Coniothyrium, Trichoderma, and Verticillium are recognized as being among the most successful fungal biocontrol agents [94,95,96]. A great deal of research has been performed, particularly on Trichoderma, owing to its diversity, abundant and frequent presence in many local environments, and ability to colonize all parts of the plants and substantially modulate plant responses to biotic and abiotic stresses [97,98,99]. Nowadays, many companies are developing Trichoderma-based commercial biocontrol products around the world, for example, T. harzianum strain T-22 (Bioworks, Geneva, Switzerland, New York, NY, USA and TGT Inc., New York, NY, USA), T. virens (Grace-Sierra Co., Baltimore, MD, USA), T. viride (Ecosense Laboratories, Mumbai, India), and T. parceramosum (BioSpark Corporation, Laguna, Philippines) [100].
It is also worth noting that the effectiveness of biological control is influenced by a variety of factors, and as such, success in this area is challenging. Most of the time, environmental conditions—temperature and relative humidity—have been showcased. However, solid edaphic factors, age and plant specificity, and the type and density of the inoculum also affect endophytic colonization [32,56]. For instance, in one study, Trutmann and Keane [101] found that the spore germination and infection (with Sclerotinia sclerotiorum) process of Trichoderma koningii was highly dependent on the pH and the temperature. They noticed that endophytic fungi germination and infection declined after pH 6 and at temperatures between 7 and 35 °C. Furthermore, the optimum temperature for germination was proven to be between 15 and 30 °C, and for infection of sclerotia, between 20 and 35 °C. In another study, Sutton et al. [58] indicated that the biocontrol activity of Gliocladium roseum against Botrytis cinerea was mainly dependent on the temperature conditions, where the activity was highest at 20 and 25 °C, but progressively decreased at 15 and 10 °C. Conventionally, before releasing biocontrol agents for commercial usage, further assessments are needed to identify the growth medium (e.g., the composition also, pH, and sterility), effective formulation (e.g., powder, liquid, or granule), and the method of application, e.g., soil, seed, and vegetative part inoculation (foliar spraying and transplant dip), as these are the other key factors for the survivability of the endophyte in the field as well as for their sufficient colonization [102,103]. Formulations based on carriers frequently have a short shelf life, are of poor quality, and may have a greatly diminished antagonistic effect on endophytic fungi. Different substrates are now utilized as carriers to enhance quality, extend shelf life, and boost the activity of potent microbes [104]. Looking at the development of formulations for Trichoderma asperellum, Kodithuwakku and Wijekoon [105] developed both liquid and solid media. Each liquid medium contained 1% sucrose solution, 1% peptone water, 1% tryptone broth, and 1% tryptone soy broth and sterilized distilled water. Meanwhile, the solid media contained sterilized talc powder. In both, spore suspension of the endophyte was employed. However, they obtained negative results for all the liquid formulations due to the heavy contamination after four weeks of storage, noticeably reducing the spore suspension. Interestingly, talc powder showed preservation of spores for three months in a talc-based formulation stored under 25–30 °C in polypropylene bags without adding preservatives. Moreover, Kodithuwakku and Wijekoon [105] revealed that talc with sterilized cattle manure had proved to be an effective multiplication substrate for T. asperellum for commercial production. In a study, Thangavelu et al. [106] recognized that soil application of T. harzianum in dried banana leaves (treated with jaggery solution) shows the stimulation of the endophyte growth over the talc-based formulation. Thangavelu and co-workers [106] observed that dried banana leaf formulations and talc-based formulations had a maximum of 1011 CFU/g and 107 CFU/g Trichoderma sp. in soil, respectively, 60 days after treatment. This was above the minimum requirement of Trichoderma sp. (105 CFU/g) in the soil to achieve effective disease control.
3.4. Control Mechanism of Phytopathogenic Fungi by Endophytic Fungi
Endophytic fungi use different modes of action to control phytopathogenic fungi, including mycoparasitism, competition for nutrients and ecological niches, antibiosis, rhizosphere colonization, and induction of the plant defense system [107,108]. Generally, many endophytic fungi may utilize a combination of all the above methods, (e.g., Fusarium oxysporum strain Fo47), resulting in a greater level of antagonism [15].
3.4.1. Mycoparasitism
In mycoparasitism, the endophytic fungi safeguard the ecology of the host by directly attacking the phytopathogenic fungi. Generally, mycoparasitic interaction includes recognition of the host, development towards the host, attachment, coiling around the host, penetration, and acquisition of nutrients. Spores of endophytic fungi can come into contact with the host fungi, and trigger the germination, protrusion of the germ tube, and further development towards the host and physical pressure allow penetration to occur [101]. Once extensive mycelia are available, when the host-derived signal is received (e.g., short oligomers, characteristically chitin, and β-1,3-glucan), it is recognized first by mycoparasitic fungi via the receptors located on their cell surface. Then, the chemotropic growth of the endophytic fungal mycelium toward the prey fungi takes place by sensing lectins released by the phytopathogenic fungi [109]. Often, endophytic fungi grow alongside/parallel to the host hyphae and branch out extensively, forming hyphal tips that are hooked and attached, and coiling more loosely/compactly or massively around them [90,110,111]. Penetration even can be occurred immediately after the hyphal contact in the absence of coiling. Conventionally, coiling happens due to defense by the host against penetration [111,112,113]. Additionally, tight coiling leads to complete loss of the pathogen’s turgidity, resulting in considerable cell collapse, and they start to shrink/wrinkle. However, such coiling will not happen if the phytopathogenic fungi are damaged or dead. Once the initial contact occurs, the fungi host starts to deform, at which pint hyphae become slightly granular [101,110].
Contact between the mycohost/prey and its parasitic fungi is made possible by lectins and proteins harboring cellulose binding modules present in their hyphae, respectively. This interaction helps trigger a signaling cascade comprising G-proteins and Mitogen-activated protein kinases (MAPKs) that can modulate the activities of as-yet-unknown transcription factors (TFs). These factors contribute to the constitutive expression of genes that encode enzymes responsible for the biosynthesis of secondary metabolites and the lysis of cell walls [114,115]. G-protein signaling pathways elicit cellular responses like cell division, growth, and further pathogenic development [109].
After this initial interaction, the endophyte begins to penetrate through the fungal cell wall, using mechanical pressure driven by hyphae and aspersoria (or similar structures), reinforced by a wide array of cell wall lytic enzymes, including chitinases, glucanases, and proteinases [101,116]. Dugan et al. [117] observed profuse coils and appressoria of Clonostachys rosea during infection of Alternaria infectoria, Alternaria tenuissima, Stemphylium sp., and Ulocladium consortiale. Similarly, Abdel-Rahim and Abo-Elyousr [90] reported the presence of appressoria (also called pseudo-appressoria, as they are not individualized cells) at the penetration site of Talaromyces pinophilus on Botrytis cinerea. In contrast, Trutmann and Keane [101] failed to detect any appressoria-like structures supporting the penetration of Trichoderma koningii hyphae while they were parasitic in Sclerotinia sclerotiorum. Pisi et al. [110] found that Trichoderma harzianum produced pincer-shaped structures supporting penetration on Fusarium graminearum. Similarly, they observed these structures when interactions occurred between Penicillium frequentans and Fusarium nivale.
In order to degrade the fungal cell wall completely, the coordinative work of all aforementioned lytic enzymes may be needed [116]. Chet and Baker [118] presented the biological mechanism, and according to their findings, when the Trichoderma hamatum and Rhizoctonia solani were cultured together in a petri dish, T. hamatum attacked the mycelium of R. solani through the chitinases and β-(1-3) glucanase. Chitinases break down the glycosidic bonds in chitin, which is among the major components of the fungal cell wall. For example, in filamentous fungi Aspergillus spp., it accounts for up to 10–20% of the cell wall dry weight [119]. Seidl-Seiboth and co-authors [120] showed that chitinases of Trichoderma species can be divided into three main groups, A, B, and C. These can be divided into subgroups A2, A4, A5, B1, B2, B5, C1, and C2, where the A5, B1, and B2 subgroups contain biochemically characterized members with chitinase activities. This may imply that numerous chitinase isozymes work together to cause the cell wall degradation of phytopathogenic fungi. Advancement of the molecular techniques led to a novel insight into chitinases; initially, for example, it was believed that in group A, 42-kDa endochitinase (Ech42) played a major role in cell wall degradation [121]; however, today it is recognized that it is also expressed during carbon starvation [122] and autolysis [123]. It is clear that Ech42 is not a mycoparasitic-specific chitinase. In group C, some subgroups are involved in a killer-toxin-like mechanism for permeabilizing antagonist cell walls during interactions between fungi [120]. Glucanase is needed to degrade α and β-glucans polysaccharides present in the phytopathogenic fungi cell wall [124]. Nevertheless, β-glucan (majorly β-(1,3)-glucan) accounted for between 30% and 80% of the cell wall dry weight, depending on the fungal species [125]. Thus, as highlighted above, chitinases and β-(1-3) glucanase are the primary enzymes playing a major role in the lysis of phytopathogenic fungal cell walls, particularly during the antagonistic action of Trichoderma spp. [126]. While proteases cleave peptide bonds in proteinaceous substrates, 20–30% of the dry weight of the cell wall of the filamentous fungi is made up of the proteins; this even rises to 30–50% in some cases in yeast-like fungi [127]. A comprehensive systematic review by Bezerra et al. [128] reported many protease studies of endophytic fungi. Nonetheless, endophytic fungi need to protect themselves against the host’s hydrolytic enzymes during mycoparasitism. For instance, in a recent study, Romero-Contreras et al. [129] found that Lysin motif (LysM) effectors were involved in resistance against chitinase activity, protecting Trichoderma atroviride from the chitinases of its mycohosts.
3.4.2. Competition for Nutrition and Ecological Niches
It has long been recognized that niche complementarities could be important factors in the coexistence of species [130]. Competitive exclusion, which states that two species cannot coexist in the same ecological niche, applies to fungi in the genus Trichoderma, which has been found to have the niche most comparable to that of Colletotrichum spp., thus eliminating the latter phytopathogenic species [131]. In turn, Trichoderma spp. have been identified as extremely fast colonizers, and are thought of as fierce competitors, keeping out slower-growing pathogens. The further ability to acquire nutrition from various substrates adds value for them [132]. Oszust et al. [131], on the basis of an in vitro assay, found that Trichoderma spp. nutritionally outcompeted (e.g., adonitol, D-arabitol, i-erythritol, glycerol, D-mannitol, and D-sorbitol) Botrytis sp., Verticillium sp., and Phytophthora sp. In a separate study, Sutton and co-authors [58] reported that, rather than being mycoparasitic, Gliocladium roseum acts as a nutrient competitor in controlling Botrytis cinerea. Morandi et al. [133] found that the nonpathogenic endophyte Clonostachys rosea controlled B. cinerea by suppressing the development and sporulation potential. To achieve this, C. rosea competes for nutrients that are in the moisture films on wounded leaves. Clonostachys rosea shows greater aggressiveness than the pathogen, and B. cinerea is eliminated owing to nutrition deprivation. Moreover, according to Morandi and colleagues [133], C. rosea inhibited B. cinerea colonization by as much as 40–50%, or even more, and conidiophore production of the pathogen was inhibited by 99–100%.
3.4.3. Antibiosis
Endophytic fungi inhibit phytopathogens through antibiosis, producing various antimicrobial chemical compounds, particularly secondary metabolites such as alkaloids, flavonoids, isocoumarins, lignans, peptides, phenolics, phenylpropanoids, quinones, steroids, terpenoids, volatile compounds, and so on [134,135]. Du et al. [66] recognized that many of the endophytic fungi of Ascomycota and Basidiomycota have a relatively high level of non-volatile-compound alkaloids, thus showing higher antimicrobial effects. In a separate study, Wu et al. [136] showed the effect of terpenoids extracted from Xylaria sp. isolation: nine oxygenated guaiane-type sesquiterpenes and three isopimarane diterpenes. Those guaiane-type sesquiterpenes presented moderate antifungal effect against Candida albicans and Hormodendrum compactum; however, more considerable inhibitory activity was demonstrated against C. albicans and Pyricularia oryzae by the diterpenes. Daroodi et al. [77] found that endophytic fungi produced volatile and non-volatile compounds; hence, the antibiosis was greater. Notably, antibiosis not only destroys the fungi mycelium, it also inhibits the germination of resistant structures like sclerotia [101]. Shi et al. [137] demonstrated the role of peptaibols, a family of peptides from Trichoderma pseudokoningii, against several pathogenic fungi. They demonstrated that peptaibols induced extensive apoptotic programmed cell death in the selected model organism, Fusarium oxysporum, while displaying strong antifungal activity in other studied species, Ascochyta citrullina and Botrytis cinerea. In a recent study, Yang et al. [138] found evidence of the higher antifungal activity of three volatile compounds, namely, 2-methoxy-4-vinylphenol (methoxyphenols), 3,4-dimethoxystyrol, and (-)-trans-caryophyllene, generated by Sarocladium brachiariae against Fusarium oxysporum. In addition, 2-methoxy-4-vinylphenol showed the strongest inhibition capacity, while (-)-trans-caryophyllene showed the least.
Kelemu et al. [139] isolated Acremonium implicatum fungus from Brachiaria grasses, showing the inhibition activity of cultured Drechslera sp. In a similar study, Gama and co-workers [140] evaluated the antifungal effect of several endophytic fungi (e.g., Paraconiothyrium sp., Sarocladium kiliense, Acremonium curvulum, Setophoma terrestris, Dissoconium sp., and Cladosporium flabelliforme) isolated from the Brachiaria grasses against Sclerotinia sclerotiorum. Mejía et al. [141] experimented with the antibiosis of fungal endophyte isolates from Cacao trees (Theobroma cacao) against Moniliophthora roreri, and reported that 13% of the tested morphospecies showed clear antibiosis. Additionally, extensive studies conducted by Bailey et al. [142], Harwoko et al. [86], Zhao et al. [81], and Zhao et al. [78] recognized the antibiosis effect of endophytic fungi against phytopathogens.
3.4.4. Induction of Plant Defense System
Plants attempt to avoid the damage caused by phytopathogens through plant defense mechanisms. Pre-existing defense structures (e.g., cuticles and wax layers on plant leaves/stems, epidermal cell walls, thick-walled tissues) and biochemical compounds (e.g., exudates) initially restrict pathogen invasion; however, pathogens can generally overcome these mechanisms. Thus, induced defense mechanisms respond to pathogens, upon infection, by forming cytoplasmic, cellular, and histological defense structures, deposition of callose, formation of abscission and cork layers, formation of tyloses, and deposition of gum. Meanwhile, induced biochemical defense mechanisms include the production of various proteins, phenolic compounds, and hypersensitive responses [143]. In order to induce the plant defense system, endophytic fungi need to enter the host plant. To achieve this, the endophytes must get beyond the initial line of resistance provided by the plant immune system. This first layer of the defense system involves plants recognizing conserved molecules that are shared by microorganisms, referred to as microbe- or pathogen-associated molecular patterns (PAMPs or MAMPs). These PAMPs are recognized on the surface of plant cells by pattern recognition receptors (PRRs). Chitin-specific receptors (PR-3) in plants recognize chitin oligomers formed on the cell wall of endophytic fungi, and trigger further defensive response [16,144]. Additionally, chitosan, a chemical derived from chitin, which is also present in the endophytic cell wall, has also been found to trigger plant defense responses [145,146]. Endophytic fungi continue to induce PRR signaling and lead to the accumulation of plant antimicrobial compounds, as well as enzymes that disrupt pathogen cell structures [91].
Following PRR activation by endophytic fungi, alteration in phytohormone biosynthesis occurs, and plant cell walls are reinforced by callose deposition [17]. Furthermore, among the phytohormones, salicylic acid (SA) and jasmonic acid (JA) are central defense signaling molecules that regulate the plant’s defense responses to pathogens [147]. Both SA and JA have the ability to increase the activity of the enzymes in plants’ phenylpropane pathway and promote the production of phenolic compounds (e.g., coumarins, flavonoids, lignin, tannins) when PRR recognize the pathogens, initiating PAMP-triggered immunity (PTI) in plants, a long-lasting defense response [147,148,149,150]. In addition to the two aforementioned hormones, ethylene (ET) and abscisic acid (ABA) have been found to be implicated in plant defense signaling pathways, also possibly involving auxin, gibberellic acid (GA), cytokinin (CK), brassinosteroids, and peptide hormones [151]. In a study, Agostini et al. [152] indicated the role played by Trichoderma atroviride in maize (Zea mays), inducing SA, JA, and ABA synthesis pathways against Fusarium verticillioides. In a similar study, Ren and Dai [153] recognized that in addition to inducing JA biosynthesis in Atractylodes lancea as a result of interaction with Gilmaniella sp., the plant also synthesized volatile antimicrobial oils containing atractylone, hinesol, β-eudesmol, and atractylodin.
Note that endophytic fungi increase the production of enzymes involved in defense-related and cell-wall degrading enzymes. Baiyee et al. [91] found that Trichoderma asperellum induced the production of defense-related enzymes (peroxidase, polyphenol oxidase) and cell-wall-degrading enzymes in lettuce (Lactuca sativa) against leaf spot fungi. It is well known that peroxidases contribute significantly to the formation of lignin and are in charge of destroying excess hydrogen peroxide produced in plant tissues as a result of pathogen attacks. Meanwhile, polyphenol oxidase aids in preventing major oxidative damage when a plant responds to disease by catalyzing the oxygen-dependent oxidation of phenols to quinones [91,154]. Endophytic fungi need to establish compatible interaction with the plant while eliciting PTI. Therefore, the fungi should be able to cope with or suppress PTI that works against them. Endophytes use proteins secreted by effectors to protect them from the host immune system [144].
Those endophytic effectors activate the next phase of the plant immunity system, called effector-triggered immunity (ETI). Once the fungi produce the effectors, they are recognized by plant-resistance (R) proteins determined by disease-resistance (R) genes. Those R proteins have two conserved features, nucleotide binding (NB) and leucine-rich repeat (LRR) domains, called NLRs [155]. In plants, NLRs genes account for over 80% of identified R genes. A range of intracellular multi-domain proteins that directly or indirectly identify pathogen-derived effectors is encoded by the NLRs genes. Identifying effectors by the NLRs receptors leads to ETI [156]. The defense reaction of ETI is similar to that of PTI; nevertheless, to activate the complete defense-resistant mechanism in plants, PTI itself may not be enough, and a cooperative function with ETI is needed [157]. Endophytic fungi have adapted balanced antagonism, which equalizes the plant defense and virulence of endophytic fungi. Secondary metabolites produced by endophytes allow them to neutralize unwelcome plant defense responses; therefore, no disease symptoms are expressed by the plant, confirming the survivability of the endophytic fungi, and favoring endosymbiosis [158,159]. In turn, phytopathogenic fungi are affected by the readily available defense reactions, thus controlling the early stage of the infection.
4. Conclusions and Prospects
In light of the study findings, it is crystal clear that a wide range of endophytic fungi can serve as alternative sources of biocontrol agents, presenting an option for controlling certain plant diseases in a variety of ways; at the same time, they can produce a range of bioactive compounds that are beneficial to plants. Characterizing the potential endophytic fungi through in vitro experiments is an essential initial step in developing biocontrol agents, and field experiments also need to be performed under different environmental conditions before they are released as commercial products. Most research to date has taken place in controlled environments, and it is not yet known how the endophyte–pathogen interaction will develop when environmental conditions change and when in competition with other organisms in the field. Among the identified potential biological control agents, species from the genus Trichoderma have been studied extensively, although many other equally effective organisms from other endophytic groups have not been adequately considered. There is also a huge lack of primary studies aimed at understanding novel endophytic fungi with bio-controlling activity, and continuous investigations are needed in this regard.
Control of those pathogens is being carried out using synthetic fungicides that cause negative impacts on ecosystems. According to the available studies, endophytic fungi better control many deleterious diseases caused by phytopathogens than synthetic fungicides; however, environmental dependency makes them more vulnerable. Consequently, in an open-field setting, we recommend applying endophytic fungi as biocontrol agents and other disease precaution measurements. Endophytic fungi were found to be a golden alternative source to the application of fungicides. Undeniably, the utilization of endophytic fungi could lead to more eco-friendly agro farming.
Author Contributions
Conceptualization, A.K.H.P., S.C.K. and S.T.; methodology, A.K.H.P., S.C.K., L.L. and S.T.; validation, S.C.K. and S.T.; investigation, A.K.H.P. and S.T.; resources, A.K.H.P.; writing—original draft preparation, A.K.H.P. and S.T.; writing—review and editing, A.K.H.P., S.C.K., L.L. and S.T.; visualization, A.K.H.P., S.C.K. and S.T.; supervision, S.C.K. and S.T.; project administration, S.C.K. and S.T.; funding acquisition, S.C.K. and S.T. All authors have read and agreed to the published version of the manuscript.
Funding
This work was supported by the National Natural Science Foundation of China grant number 32260004 and the “Yunnan Revitalization Talents Support Plan” (High-End Foreign Experts Program).
Institutional Review Board Statement
Not applicable.
Informed Consent Statement
Not applicable.
Data Availability Statement
Not applicable.
Acknowledgments
Samantha C. Karunarathna thanks the Institute of Fundamental Studies (NIFS), Hantana Road, Kandy, Sri Lanka, and Qujing Normal University for their support.
Conflicts of Interest
The authors declare no conflict of interest.
References
- Sadigov, R. Rapid Growth of the World Population and Its Socioeconomic Results. Sci. World J. 2022, 2022, 8110229. [Google Scholar] [CrossRef]
- Bongaarts, J. Human Population Growth and the Demographic Transition. Philos. Trans. R. Soc. Lond. B Biol. Sci. 2009, 364, 2985–2990. [Google Scholar] [CrossRef] [PubMed]
- Paz, D.B.; Henderson, K.; Loreau, M. Agricultural Land Use and the Sustainability of Social-Ecological Systems. Ecol. Modell. 2020, 437, 109312. [Google Scholar] [CrossRef]
- New Standards to Curb the Global Spread of Plant Pests and Diseases. FAO. Available online: https://www.fao.org/news/story/en/item/1187738/icode/ (accessed on 19 March 2023).
- Ristaino, J.B.; Anderson, P.K.; Bebber, D.P.; Brauman, K.A.; Cunniffe, N.J.; Fedoroff, N.V.; Finegold, C.; Garrett, K.A.; Gilligan, C.A.; Jones, C.M.; et al. The Persistent Threat of Emerging Plant Disease Pandemics to Global Food Security. Proc. Natl. Acad. Sci. USA 2021, 118, e2022239118. [Google Scholar] [CrossRef]
- Peng, Y.; Li, S.J.; Yan, J.; Tang, Y.; Cheng, J.P.; Gao, A.J.; Yao, X.; Ruan, J.J.; Xu, B.L. Research Progress on Phytopathogenic Fungi and Their Role as Biocontrol Agents. Front. Microbiol. 2021, 12, 670135. [Google Scholar] [CrossRef] [PubMed]
- Gullino, M.L. Coffee Rust in Ceylon: Why English People Drink Tea. In Spores; Springer: Cham, Switzerland, 2021; pp. 29–32. ISBN 9783030699949. [Google Scholar]
- Padmanabhan, S.Y. The Great Bengal Famine. Annu. Rev. Phytopathol. 1973, 11, 11–24. [Google Scholar] [CrossRef]
- Tatum, L.A. The Southern Corn Leaf Blight Epidemic: A New Race of the Fungus Helminthosporium maydis Threatens Domestic Prices and Corn Reserves for Export. Science 1971, 171, 1113–1116. [Google Scholar] [CrossRef]
- Dean, R.; Van Kan, J.A.L.; Pretorius, Z.A.; Hammond-Kosack, K.E.; Di Pietro, A.; Spanu, P.D.; Rudd, J.J.; Dickman, M.; Kahmann, R.; Ellis, J.; et al. The Top 10 Fungal Pathogens in Molecular Plant Pathology. Mol. Plant Pathol. 2012, 13, 414–430. [Google Scholar] [CrossRef] [PubMed]
- Doehlemann, G.; Ökmen, B.; Zhu, W.; Sharon, A. Plant Pathogenic Fungi. Microbiol. Spectr. 2017, 5, 1–23. [Google Scholar] [CrossRef]
- Coque, J.J.R.; Álvarez-Pérez, J.M.; Cobos, R.; González-García, S.; Ibáñez, A.M.; Diez Galán, A.; Calvo-Peña, C. Advances in the Control of Phytopathogenic Fungi That Infect Crops through Their Root System. Adv. Appl. Microbiol. 2020, 111, 123–170. [Google Scholar] [CrossRef]
- Ponce de León, I.; Montesano, M. Activation of Defense Mechanisms against Pathogens in Mosses and Flowering Plants. Int. J. Mol. Sci. 2013, 14, 3178–3200. [Google Scholar] [CrossRef] [PubMed]
- Westrick, N.M.; Smith, D.L.; Kabbage, M. Disarming the Host: Detoxification of Plant Defense Compounds during Fungal Necrotrophy. Front. Plant Sci. 2021, 12, 651716. [Google Scholar] [CrossRef]
- Brader, G.; Compant, S.; Vescio, K.; Mitter, B.; Trognitz, F.; Ma, L.-J.; Sessitsch, A. Ecology and Genomic Insights into Plant-Pathogenic and Plant-Nonpathogenic Endophytes. Annu. Rev. Phytopathol. 2017, 55, 61–83. [Google Scholar] [CrossRef]
- Khare, E.; Mishra, J.; Arora, N.K. Multifaceted Interactions between Endophytes and Plant: Developments and Prospects. Front. Microbiol. 2018, 9, 2732. [Google Scholar] [CrossRef]
- Lo Presti, L.; Lanver, D.; Schweizer, G.; Tanaka, S.; Liang, L.; Tollot, M.; Zuccaro, A.; Reissmann, S.; Kahmann, R. Fungal Effectors and Plant Susceptibility. Annu. Rev. Plant Biol. 2015, 66, 513–545. [Google Scholar] [CrossRef] [PubMed]
- Collinge, D.B.; Jensen, B.; Jørgensen, H.J. Fungal Endophytes in Plants and Their Relationship to Plant Disease. Curr. Opin. Microbiol. 2022, 69, 102177. [Google Scholar] [CrossRef]
- Gouda, S.; Das, G.; Sen, S.K.; Shin, H.-S.; Patra, J.K. Endophytes: A Treasure House of Bioactive Compounds of Medicinal Importance. Front. Microbiol. 2016, 7, 1538. [Google Scholar] [CrossRef]
- Krings, M.; Taylor, T.N.; Hass, H.; Kerp, H.; Dotzler, N.; Hermsen, E.J. Fungal Endophytes in a 400-Million-Yr-Old Land Plant: Infection Pathways, Spatial Distribution, and Host Responses. New Phytol. 2007, 174, 648–657. [Google Scholar] [CrossRef] [PubMed]
- Smith, S.A.; Tank, D.C.; Boulanger, L.-A.; Bascom-Slack, C.A.; Eisenman, K.; Kingery, D.; Babbs, B.; Fenn, K.; Greene, J.S.; Hann, B.D.; et al. Bioactive Endophytes Warrant Intensified Exploration and Conservation. PLoS ONE 2008, 3, e3052. [Google Scholar] [CrossRef] [PubMed]
- Hodgson, S.; de Cates, C.; Hodgson, J.; Morley, N.J.; Sutton, B.C.; Gange, A.C. Vertical Transmission of Fungal Endophytes Is Widespread in Forbs. Ecol. Evol. 2014, 4, 1199–1208. [Google Scholar] [CrossRef] [PubMed]
- Alam, B.; Lǐ, J.; Gě, Q.; Khan, M.A.; Gōng, J.; Mehmood, S.; Yuán, Y.; Gǒng, W. Endophytic Fungi: From Symbiosis to Secondary Metabolite Communications or Vice Versa? Front. Plant Sci. 2021, 12, 791033. [Google Scholar] [CrossRef]
- Rashmi, M.; Kushveer, J.S.; Sarma, V.V. A Worldwide List of Endophytic Fungi with Notes on Ecology and Diversity. Mycosphere 2019, 10, 798–1079. [Google Scholar] [CrossRef]
- Baron, N.C.; Rigobelo, E.C. Endophytic Fungi: A Tool for Plant Growth Promotion and Sustainable Agriculture. Mycology 2022, 13, 39–55. [Google Scholar] [CrossRef]
- Digra, S.; Nonzom, S. An Insight into Endophytic Antimicrobial Compounds: An Updated Analysis. Plant Biotechnol. Rep. 2023. [Google Scholar] [CrossRef]
- Shahzad, R.; Khan, A.L.; Bilal, S.; Asaf, S.; Lee, I.-J. What Is There in Seeds? Vertically Transmitted Endophytic Resources for Sustainable Improvement in Plant Growth. Front. Plant Sci. 2018, 9, 24. [Google Scholar] [CrossRef] [PubMed]
- Stierle, A.; Strobel, G.; Stierle, D. Taxol and Taxane Production by Taxomyces andreanae, an Endophytic Fungus of Pacific Yew. Science 1993, 260, 214–216. [Google Scholar] [CrossRef]
- Zhang, Y.; Han, T.; Ming, Q.; Wu, L.; Rahman, K.; Qin, L. Alkaloids Produced by Endophytic Fungi: A Review. Nat. Prod. Commun. 2012, 7, 963–968. [Google Scholar] [CrossRef]
- Adeleke, B.S.; Babalola, O.O. Pharmacological Potential of Fungal Endophytes Associated with Medicinal Plants: A Review. J. Fungi 2021, 7, 147. [Google Scholar] [CrossRef]
- Tumangger, B.S.; Nadilla, F.; Baiduri, N.; Fitriani; Mardina, V. In Vitro Screening of Endophytic Fungi Associated with Mangroveas Biofertilizer on the Growth of Black Rice (Oryza sativa L. “Cempo Ireng”). IOP Conf. Ser. Mater. Sci. Eng. 2018, 420, 012080. [Google Scholar] [CrossRef]
- Bamisile, B.S.; Dash, C.K.; Akutse, K.S.; Keppanan, R.; Wang, L. Fungal Endophytes: Beyond Herbivore Management. Front. Microbiol. 2018, 9, 544. [Google Scholar] [CrossRef] [PubMed]
- Bhadra, F.; Gupta, A.; Vasundhara, M.; Reddy, M.S. Endophytic Fungi: A Potential Source of Industrial Enzyme Producers. 3 Biotech 2022, 12, 86. [Google Scholar] [CrossRef]
- Aktar, M.W.; Sengupta, D.; Chowdhury, A. Impact of Pesticides Use in Agriculture: Their Benefits and Hazards. Interdiscip. Toxicol. 2009, 2, 1–12. [Google Scholar] [CrossRef]
- Tudi, M.; Daniel Ruan, H.; Wang, L.; Lyu, J.; Sadler, R.; Connell, D.; Chu, C.; Phung, D.T. Agriculture Development, Pesticide Application and Its Impact on the Environment. Int. J. Environ. Res. Public Health 2021, 18, 1112. [Google Scholar] [CrossRef]
- Priyashantha, A.K.H.; Attanayake, R.N. Can Anaerobic Soil Disinfestation (ASD) be a Game Changer in Tropical Agriculture? Pathogens 2021, 10, 133. [Google Scholar] [CrossRef] [PubMed]
- Kalyabina, V.P.; Esimbekova, E.N.; Kopylova, K.V.; Kratasyuk, V.A. Pesticides: Formulants, Distribution Pathways and Effects on Human Health-A Review. Toxicol. Rep. 2021, 8, 1179–1192. [Google Scholar] [CrossRef] [PubMed]
- Liu, P.; Zheng, X.; Shangguan, S.; Zhao, L.; Fang, X.; Huang, Y.; Hermanowicz, S.W. Public Perceptions and Willingness-to-Pay for Nanopesticides. Nanomaterials 2022, 12, 1292. [Google Scholar] [CrossRef] [PubMed]
- Garcia, S.D.; Strieder, D.M. Perceptions about Exposure to Pesticides among Rural School Students: Identified Controversies. Rev. Bras. Enferm. 2023, 76, e20220101. [Google Scholar] [CrossRef]
- Ashkani, S.; Rafii, M.Y.; Shabanimofrad, M.; Miah, G.; Sahebi, M.; Azizi, P.; Tanweer, F.A.; Akhtar, M.S.; Nasehi, A. Molecular Breeding Strategy and Challenges towards Improvement of Blast Disease Resistance in Rice Crop. Front. Plant Sci. 2015, 6, 886. [Google Scholar] [CrossRef]
- Carolan, K.; Helps, J.; van den Berg, F.; Bain, R.; Paveley, N.; van den Bosch, F. Extending the Durability of Cultivar Resistance by Limiting Epidemic Growth Rates. Proc. Biol. Sci. 2017, 284, 20170828. [Google Scholar] [CrossRef]
- Fontana, D.C.; de Paula, S.; Torres, A.G.; de Souza, V.H.M.; Pascholati, S.F.; Schmidt, D.; Dourado Neto, D. Endophytic Fungi: Biological Control and Induced Resistance to Phytopathogens and Abiotic Stresses. Pathogens 2021, 10, 570. [Google Scholar] [CrossRef]
- Hernandez-Tenorio, F.; Miranda, A.M.; Rodríguez, C.A.; Giraldo-Estrada, C.; Sáez, A.A. Potential Strategies in the Biopesticide Formulations: A Bibliometric Analysis. Agronomy 2022, 12, 2665. [Google Scholar] [CrossRef]
- Van Dam, P.; de Sain, M.; ter Horst, A.; van der Gragt, M.; Rep, M. Use of Comparative Genomics-Based Markers for Discrimination of Host Specificity in Fusarium oxysporum. Appl. Environ. Microbiol. 2018, 84, e01868-17. [Google Scholar] [CrossRef] [PubMed]
- De Lamo, F.J.; Takken, F.L.W. Biocontrol by Fusarium oxysporum Using Endophyte-Mediated Resistance. Front. Plant Sci. 2020, 11, 37. [Google Scholar] [CrossRef] [PubMed]
- Lahlali, R.; Ezrari, S.; Radouane, N.; Kenfaoui, J.; Esmaeel, Q.; El Hamss, H.; Belabess, Z.; Barka, E.A. Biological Control of Plant Pathogens: A Global Perspective. Microorganisms 2022, 10, 596. [Google Scholar] [CrossRef] [PubMed]
- Bale, J.S.; van Lenteren, J.C.; Bigler, F. Biological Control and Sustainable Food Production. Philos. Trans. R. Soc. Lond. B Biol. Sci. 2008, 363, 761–776. [Google Scholar] [CrossRef] [PubMed]
- Pandit, M.A.; Kumar, J.; Gulati, S.; Bhandari, N.; Mehta, P.; Katyal, R.; Rawat, C.D.; Mishra, V.; Kaur, J. Major Biological Control Strategies for Plant Pathogens. Pathogens 2022, 11, 273. [Google Scholar] [CrossRef]
- Niu, B.; Wang, W.; Yuan, Z.; Sederoff, R.R.; Sederoff, H.; Chiang, V.L.; Borriss, R. Microbial Interactions within Multiple-Strain Biological Control Agents Impact Soil-Borne Plant Disease. Front. Microbiol. 2020, 11, 585404. [Google Scholar] [CrossRef]
- He, D.-C.; He, M.-H.; Amalin, D.M.; Liu, W.; Alvindia, D.G.; Zhan, J. Biological Control of Plant Diseases: An Evolutionary and Eco-Economic Consideration. Pathogens 2021, 10, 1311. [Google Scholar] [CrossRef]
- Akram, S.; Ahmed, A.; He, P.; He, P.; Liu, Y.; Wu, Y.; Munir, S.; He, Y. Uniting the Role of Endophytic Fungi against Plant Pathogens and Their Interaction. J. Fungi 2023, 9, 72. [Google Scholar] [CrossRef]
- Köhl, J.; Kolnaar, R.; Ravensberg, W.J. Mode of Action of Microbial Biological Control Agents against Plant Diseases: Relevance beyond Efficacy. Front. Plant Sci. 2019, 10, 845. [Google Scholar] [CrossRef]
- Thambugala, K.M.; Daranagama, D.A.; Phillips, A.J.L.; Kannangara, S.D.; Promputtha, I. Fungi vs. Fungi in Biocontrol: An Overview of Fungal Antagonists Applied against Fungal Plant Pathogens. Front. Cell. Infect. Microbiol. 2020, 10, 604923. [Google Scholar] [CrossRef]
- Segaran, G.; Sathiavelu, M. Fungal Endophytes: A Potent Biocontrol Agent and a Bioactive Metabolites Reservoir. Biocatal. Agric. Biotechnol. 2019, 21, 101284. [Google Scholar] [CrossRef]
- Maloy, O.C.; Lang, K.J. Carl Freiherr von Tubeuf: Pioneer in Biological Control of Plant Diseases. Annu. Rev. Phytopathol. 2003, 41, 41–52. [Google Scholar] [CrossRef]
- Rabiey, M.; Hailey, L.E.; Roy, S.R.; Grenz, K.; Al-Zadjali, M.A.S.; Barrett, G.A.; Jackson, R.W. Endophytes vs Tree Pathogens and Pests: Can They Be Used as Biological Control Agents to Improve Tree Health? Eur. J. Plant Pathol. 2019, 155, 711–729. [Google Scholar] [CrossRef]
- Weindling, R. Trichoderma lignorum As a Parasite of Other Soil Fungi. Phytopathology 1932, 22, 837–845. [Google Scholar]
- Sutton, J.C.; Li, D.-W.; Peng, G.; Yu, H.; Zhang, P.; Valdebenito-Sanhueza, R.M. Gliocladium roseum a Versatile Adversary of Botrytis cinerea in Crops. Plant Dis. 1997, 81, 316–328. [Google Scholar] [CrossRef] [PubMed]
- Andrews, J.H. Biological Control in the Phyllosphere. Annu. Rev. Phytopathol. 1992, 30, 603–635. [Google Scholar] [CrossRef] [PubMed]
- Rajani, P.; Rajasekaran, C.; Vasanthakumari, M.M.; Olsson, S.B.; Ravikanth, G.; Uma Shaanker, R. Inhibition of Plant Pathogenic Fungi by Endophytic Trichoderma spp. through Mycoparasitism and Volatile Organic Compounds. Microbiol. Res. 2021, 242, 126595. [Google Scholar] [CrossRef] [PubMed]
- Kiss, L. A Review of Fungal Antagonists of Powdery Mildews and Their Potential as Biocontrol Agents. Pest Manag. Sci. 2003, 59, 475–483. [Google Scholar] [CrossRef]
- Yao, Y.Q.; Lan, F.; Qiao, Y.M.; Wei, J.G.; Huang, R.S.; Li, L.B. Endophytic Fungi Harbored in the Root of Sophora tonkinensis Gapnep: Diversity and Biocontrol Potential against Phytopathogens. MicrobiologyOpen 2017, 6, e00437. [Google Scholar] [CrossRef]
- Schulz, B.; Wanke, U.; Draeger, S.; Aust, H.-J. Endophytes from Herbaceous Plants and Shrubs: Effectiveness of Surface Sterilization Methods. Mycol. Res. 1993, 97, 1447–1450. [Google Scholar] [CrossRef]
- Sahu, P.K.; Tilgam, J.; Mishra, S.; Hamid, S.; Gupta, A.; Jayalakshmi, K.; Verma, S.K.; Kharwar, R.N. Surface Sterilization for Isolation of Endophytes: Ensuring What (Not) to Grow. J. Basic Microbiol. 2022, 62, 647–668. [Google Scholar] [CrossRef] [PubMed]
- Tibpromma, S.; Hyde, K.D.; Bhat, J.D.; Mortimer, P.E.; Xu, J.; Promputtha, I.; Doilom, M.; Yang, J.-B.; Tang, A.M.C.; Karunarathna, S.C. Identification of Endophytic Fungi from Leaves of Pandanaceae Based on Their Morphotypes and DNA Sequence Data from Southern Thailand. MycoKeys 2018, 33, 25–67. [Google Scholar] [CrossRef] [PubMed]
- Du, W.; Yao, Z.; Li, J.; Sun, C.; Xia, J.; Wang, B.; Shi, D.; Ren, L. Diversity and Antimicrobial Activity of Endophytic Fungi Isolated from Securinega suffruticosa in the Yellow River Delta. PLoS ONE 2020, 15, e0229589. [Google Scholar] [CrossRef] [PubMed]
- Dos Reis, J.B.A.; Lorenzi, A.S.; do Vale, H.M.M. Methods Used for the Study of Endophytic Fungi: A Review on Methodologies and Challenges, and Associated Tips. Arch. Microbiol. 2022, 204, 675. [Google Scholar] [CrossRef] [PubMed]
- Wulandari, A.P.; Triani, E.; Sari, K.; Prasetyani, M.; Nurzaman, M.; Purwati, R.D.; Ermawar, R.A.; Nuraini, A. Endophytic Microbiome of Boehmeria nivea and Their Antagonism against Latent Fungal Pathogens in Plants. BMC Microbiol. 2022, 22, 320. [Google Scholar] [CrossRef]
- De Almeida, A.B.; Concas, J.; Campos, M.D.; Materatski, P.; Varanda, C.; Patanita, M.; Murolo, S.; Romanazzi, G.; Félix, M.d.R. Endophytic Fungi as Potential Biological Control Agents against Grapevine Trunk Diseases in Alentejo Region. Biology 2020, 9, 420. [Google Scholar] [CrossRef]
- De Carvalho, C.R.; Ferreira-D’Silva, A.; Wedge, D.E.; Cantrell, C.L.; Rosa, L.H. Antifungal Activities of Cytochalasins Produced by Diaporthe miriciae, an Endophytic Fungus Associated with Tropical Medicinal Plants. Can. J. Microbiol. 2018, 64, 835–843. [Google Scholar] [CrossRef]
- Kapoor, N.; Ntemafack, A.; Chouhan, R.; Gandhi, S.G. Anti-Phytopathogenic and Plant Growth Promoting Potential of Endophytic Fungi Isolated from Dysoxylum gotadhora. Arch. Phytopathol. Pflanzenschutz 2022, 55, 454–473. [Google Scholar] [CrossRef]
- Azuddin, N.F.; Mohd, M.H.; Rosely, N.F.N.; Mansor, A.; Zakaria, L. Molecular Phylogeny of Endophytic Fungi from Rattan (Calamus castaneus Griff.) Spines and Their Antagonistic Activities against Plant Pathogenic Fungi. J. Fungi 2021, 7, 301. [Google Scholar] [CrossRef]
- Zhao, X.; Song, P.; Hou, D.; Li, Z.; Hu, Z. Antifungal Activity, Identification and Biosynthetic Potential Analysis of Fungi against Rhizoctonia cerealis. Ann. Microbiol. 2021, 71, 41. [Google Scholar] [CrossRef]
- Morais, E.M.; Silva, A.A.R.; de Sousa, F.W.A.; de Azevedo, I.M.B.; Silva, H.F.; Santos, A.M.G.; Beserra Júnior, J.E.A.; de Carvalho, C.P.; Eberlin, M.N.; Porcari, A.M.; et al. Endophytic Trichoderma Strains Isolated from Forest Species of the Cerrado-Caatinga Ecotone Are Potential Biocontrol Agents against Crop Pathogenic Fungi. PLoS ONE 2022, 17, e0265824. [Google Scholar] [CrossRef]
- Rabha, A.J.; Naglot, A.; Sharma, G.D.; Gogoi, H.K.; Veer, V. In Vitro Evaluation of Antagonism of Endophytic Colletotrichum gloeosporioides against Potent Fungal Pathogens of Camellia sinensis. Indian J. Microbiol. 2014, 54, 302–309. [Google Scholar] [CrossRef]
- Xu, S.; Li, M.; Hu, Z.; Shao, Y.; Ying, J.; Zhang, H. The Potential Use of Fungal Co-Culture Strategy for Discovery of New Secondary Metabolites. Microorganisms 2023, 11, 464. [Google Scholar] [CrossRef]
- Daroodi, Z.; Taheri, P.; Tarighi, S. Acrophialophora Jodhpurensis: An Endophytic Plant Growth Promoting Fungus with Biocontrol Effect against Alternaria alternata. Front. Plant Sci. 2022, 13, 984583. [Google Scholar] [CrossRef]
- Zhao, X.; Hu, Z.; Hou, D.; Xu, H.; Song, P. Biodiversity and Antifungal Potential of Endophytic Fungi from the Medicinal Plant Cornus officinalis. Symbiosis 2020, 81, 223–233. [Google Scholar] [CrossRef]
- Noel, Z.A.; Roze, L.V.; Breunig, M.; Trail, F. Endophytic Fungi as a Promising Biocontrol Agent to Protect Wheat from Fusarium graminearum Head Blight. Plant Dis. 2022, 106, 595–602. [Google Scholar] [CrossRef] [PubMed]
- Du, T.-Y.; Karunarathna, S.C.; Zhang, X.; Dai, D.-Q.; Mapook, A.; Suwannarach, N.; Xu, J.-C.; Stephenson, S.L.; Elgorban, A.M.; Al-Rejaie, S.; et al. Endophytic Fungi Associated with Aquilaria sinensis (Agarwood) from China Show Antagonism against Bacterial and Fungal Pathogens. J. Fungi 2022, 8, 1197. [Google Scholar] [CrossRef]
- Zhao, X.; Hou, D.; Xu, J.; Wang, K.; Hu, Z. Antagonistic Activity of Fungal Strains against Fusarium Crown Rot. Plants 2022, 11, 255. [Google Scholar] [CrossRef]
- Abro, M.A.; Sun, X.; Li, X.; Jatoi, G.H.; Guo, L.-D. Biocontrol Potential of Fungal Endophytes against Fusarium oxysporum f. sp. Cucumerinum Causing Wilt in Cucumber. Plant Pathol. J. 2019, 35, 598–608. [Google Scholar] [CrossRef] [PubMed]
- Yehia, R.S.; Osman, G.H.; Assaggaf, H.; Salem, R.; Mohamed, M.S.M. Isolation of Potential Antimicrobial Metabolites from Endophytic Fungus Cladosporium cladosporioides from Endemic Plant Zygophyllum mandavillei. S. Afr. J. Bot. 2020, 134, 296–302. [Google Scholar] [CrossRef]
- Putri, N.D.; Muhibuddin, A.; Aini, L.Q. The Potential of Endophytic Fungi in Promoting Rice Plant Growth and Suppressing Blast Disease. J. Trop. Plant Prot. 2021, 2, 41–49. [Google Scholar] [CrossRef]
- Moreira, C.C.; Luna, G.L.F.; Soriano, B.; Cavicchioli, R.; Bogas, A.C.; de Sousa, C.P.; Anibal, F.F.; Lacava, P.T. Leishmanicidal, Cytotoxic, Antimicrobial and Enzymatic Activities of Diaporthe Species, a Mangrove-Isolated Endophytic Fungus. Afr. J. Microbiol. Res. 2020, 14, 516–524. [Google Scholar] [CrossRef]
- Harwoko, H.; Daletos, G.; Stuhldreier, F.; Lee, J.; Wesselborg, S.; Feldbrügge, M.; Müller, W.E.G.; Kalscheuer, R.; Ancheeva, E.; Proksch, P. Dithiodiketopiperazine Derivatives from Endophytic Fungi Trichoderma harzianum and Epicoccum nigrum. Nat. Prod. Res. 2019, 35, 257–265. [Google Scholar] [CrossRef] [PubMed]
- Mirzaei, S.; Masumi, S. The Antimicrobial Activity of Endophytic Fungi Isolated from Thymus spp. J. Med. Plants Byprod. 2022. [Google Scholar] [CrossRef]
- Mota, S.F.; Pádua, P.F.; Ferreira, A.N.; de Barros Wanderley Gomes, L.; Dias, M.A.; Souza, E.A.; Pereira, O.L.; Cardoso, P.G. Biological Control of Common Bean Diseases Using Endophytic Induratia spp. Biol. Control 2021, 159, 104629. [Google Scholar] [CrossRef]
- Matušinsky, P.; Sedláková, B.; Bleša, D. Compatible Interaction of Brachypodium distachyon and Endophytic Fungus Microdochium bolleyi. PLoS ONE 2022, 17, e0265357. [Google Scholar] [CrossRef]
- Abdel-Rahim, I.R.; Abo-Elyousr, K.A.M. Talaromyces pinophilus Strain AUN-1 as a Novel Mycoparasite of Botrytis cinerea, the Pathogen of Onion Scape and Umbel Blights. Microbiol. Res. 2018, 212–213, 1–9. [Google Scholar] [CrossRef]
- Baiyee, B.; Ito, S.-I.; Sunpapao, A. Trichoderma asperellum T1 Mediated Antifungal Activity and Induced Defense Response against Leaf Spot Fungi in Lettuce (Lactuca sativa L.). Physiol. Mol. Plant Pathol. 2019, 106, 96–101. [Google Scholar] [CrossRef]
- Sallam, N.; Ali, E.F.; Seleim, M.A.A.; Khalil Bagy, H.M.M. Endophytic Fungi Associated with Soybean Plants and Their Antagonistic Activity against Rhizoctonia solani. Egypt. J. Biol. Pest Control 2021, 31, 54. [Google Scholar] [CrossRef]
- Brooks, S.; Klomchit, A.; Chimthai, S.; Jaidee, W.; Bastian, A.C. Xylaria feejeensis, SRNE2BP a Fungal Endophyte with Biocontrol Properties to Control Early Blight and Fusarium Wilt Disease in Tomato and Plant Growth Promotion Activity. Curr. Microbiol. 2022, 79, 108. [Google Scholar] [CrossRef] [PubMed]
- De Vrije, T.; Antoine, N.; Buitelaar, R.M.; Bruckner, S.; Dissevelt, M.; Durand, A.; Gerlagh, M.; Jones, E.E.; Lüth, P.; Oostra, J.; et al. The Fungal Biocontrol Agent Coniothyrium minitans: Production by Solid-State Fermentation, Application and Marketing. Appl. Microbiol. Biotechnol. 2001, 56, 58–68. [Google Scholar] [CrossRef] [PubMed]
- Cheng, J.; Jiang, D.; Yi, X.; Fu, Y.; Li, G.; Whipps, J.M. Production, Survival and Efficacy of Coniothyrium minitans Conidia Produced in Shaken Liquid Culture. FEMS Microbiol. Lett. 2003, 227, 127–131. [Google Scholar] [CrossRef] [PubMed]
- Sahgal, M. Fungal Enzymes in Biocontrol of Phytopathogens. In Progress in Mycology; Satyanarayana, T., Deshmukh, S.K., Deshpande, M.V., Eds.; Springer: Singapore, 2021; pp. 327–356. ISBN 9789811633065. [Google Scholar]
- Ferreira, F.V.; Musumeci, M.A. Trichoderma as Biological Control Agent: Scope and Prospects to Improve Efficacy. World J. Microbiol. Biotechnol. 2021, 37, 90. [Google Scholar] [CrossRef] [PubMed]
- Liu, Y.; He, P.; He, P.; Munir, S.; Ahmed, A.; Wu, Y.; Yang, Y.; Lu, J.; Wang, J.; Yang, J.; et al. Potential Biocontrol Efficiency of Trichoderma Species against Oomycete Pathogens. Front. Microbiol. 2022, 13, 974024. [Google Scholar] [CrossRef]
- Nascimento, V.C.; Rodrigues-Santos, K.C.; Carvalho-Alencar, K.L.; Castro, M.B.; Kruger, R.H.; Lopes, F.A.C. Trichoderma: Biological Control Efficiency and Perspectives for the Brazilian Midwest States and Tocantins. Braz. J. Biol. 2022, 82, e260161. [Google Scholar] [CrossRef]
- Cumagun, C.J.R. Managing Plant Diseases and Promoting Sustainability and Productivity with Trichoderma: The Philippine Experience. J. Agric. Sci. Tech. 2012, 14, 699–714. [Google Scholar]
- Trutmann, P.; Keane, P.J. Trichoderma koningii as a Biological Control Agent for Sclerotinia sclerotiorum in Southern Australia. Soil Biol. Biochem. 1990, 22, 43–50. [Google Scholar] [CrossRef]
- Kifle, M.H.; Yobo, K.S.; Laing, M.D. Biocontrol of Aspergillus flavus in Groundnut Using Trichoderma harzianum Stain Kd. J. Plant Dis. Prot. 2017, 124, 51–56. [Google Scholar] [CrossRef]
- Law, J.W.-F.; Ser, H.-L.; Khan, T.M.; Chuah, L.-H.; Pusparajah, P.; Chan, K.-G.; Goh, B.-H.; Lee, L.-H. The Potential of Streptomyces as Biocontrol Agents against the Rice Blast Fungus, Magnaporthe oryzae (Pyricularia oryzae). Front. Microbiol. 2017, 8, 3. [Google Scholar] [CrossRef]
- John, N.S.; Anjanadevi, I.P.; Jeeva, M.L. Efficacy of Cassava By-products as Carrier Material of Trichoderma harzianum, a Biocontrol Agent Against Sclerotium rolfsii Causing Collar Rot in Elephant Foot Yam. J. Root Crops. 2014, 40, 74–79. [Google Scholar]
- Kodithuwakku, R.D.; Wijekoon, W.M.R.W.B. Determination of Shelf-Life of Trichoderma Asperellum in Solid- and Liquid-Based Formulations. Sri Lanka J. Food Agric. 2018, 4, 15. [Google Scholar] [CrossRef]
- Thangavelu, R.; Palaniswami, A.; Velazhahan, R. Mass Production of Trichoderma harzianum for Managing Fusarium Wilt of Banana. Agric. Ecosyst. Environ. 2004, 103, 259–263. [Google Scholar] [CrossRef]
- Petros Kubheka, B.; Weldegabir Ziena, L. Trichoderma: A Biofertilizer and a Bio-Fungicide for Sustainable Crop Production. In Trichoderma—Technology and Uses; IntechOpen: London, UK, 2022; pp. 1–16. [Google Scholar]
- Guzmán-Guzmán, P.; Kumar, A.; de los Santos-Villalobos, S.; Parra-Cota, F.I.; Orozco-Mosqueda, M.d.C.; Fadiji, A.E.; Hyder, S.; Babalola, O.O.; Santoyo, G. Trichoderma Species: Our Best Fungal Allies in the Biocontrol of Plant Diseases—A Review. Plants 2023, 12, 432. [Google Scholar] [CrossRef] [PubMed]
- Omann, M.; Zeilinger, S. How a Mycoparasite Employs G-Protein Signaling: Using the Example of Trichoderma. J. Signal Transduct. 2010, 2010, 123126. [Google Scholar] [CrossRef] [PubMed]
- Pisi, A.; Roberti, R.; Zakrisson, E.; Filippini, G.; Mantovani, W.; Cesari, A. SEM Investigation about Hyphal Relationships between Some Antagonistic Fungi against Fusarium spp. Foot Rot Pathogen of Wheat. Phytopathol. Mediterr. 2001, 40, 37–44. [Google Scholar]
- Chet, I.; Harman, G.E.; Baker, R. Trichoderma hamatum: Its Hyphal Interactions with Rhizoctonia solani and Pythium spp. Microb. Ecol. 1981, 7, 29–38. Available online: http://www.jstor.org/stable/4250642 (accessed on 7 April 2023). [CrossRef]
- Gams, W.; Diederich, P.; Põldmaa, K. Fungicolous Fungi. In Biodiversity of Fungi; Mueller, G., Bills, G., Foster, M., Eds.; Elsevier: Cambridge, MA, USA, 2004; pp. 343–392. ISBN 9780125095518. [Google Scholar]
- Can, H.; Kal, U.; Kayak, N.; Dal, Y.; Turkmen, O. Use of Microbial Inoculants against Biotic Stress in Vegetable Crops: Physiological and Molecular Aspect; Sustainable Horticulture-Microbial Inoculants and Stress Interaction; Elsevier: Cambridge, MA, USA, 2022; pp. 263–332. [Google Scholar]
- Druzhinina, I.S.; Seidl-Seiboth, V.; Herrera-Estrella, A.; Horwitz, B.A.; Kenerley, C.M.; Monte, E.; Mukherjee, P.K.; Zeilinger, S.; Grigoriev, I.V.; Kubicek, C.P. Trichoderma: The Genomics of Opportunistic Success. Nat. Rev. Microbiol. 2011, 9, 749–759. [Google Scholar] [CrossRef]
- Steindorff, A.S.; Ramada, M.H.S.; Coelho, A.S.G.; Miller, R.N.G.; Pappas, G.J., Jr.; Ulhoa, C.J.; Noronha, E.F. Identification of Mycoparasitism-Related Genes against the Phytopathogen Sclerotinia sclerotiorum through Transcriptome and Expression Profile Analysis in Trichoderma harzianum. BMC Genom. 2014, 15, 204. [Google Scholar] [CrossRef]
- Gruber, S.; Seidl-Seiboth, V. Self versus Non-Self: Fungal Cell Wall Degradation in Trichoderma. Microbiology 2012, 158, 26–34. [Google Scholar] [CrossRef]
- Dugan, F.M.; Lupien, S.L.; Hernandez-Bello, M.; Peever, T.L.; Chen, W. Fungi Resident in Chickpea Debris and Their Suppression of Growth and Reproduction of Didymella rabiei under Laboratory Conditions. J. Phytopathol. 2005, 153, 431–439. [Google Scholar] [CrossRef]
- Chet, I.; Baker, R. Isolation and Biocontrol Potential of Trichoderma hamatum from Soil Naturally Suppressive to Rhizoctonia solani. Phytopathology 1981, 71, 286–290. [Google Scholar] [CrossRef]
- Gong, Z.; Zhang, S.; Liu, J. Recent Advances in Chitin Biosynthesis Associated with the Morphology and Secondary Metabolite Synthesis of Filamentous Fungi in Submerged Fermentation. J. Fungi 2023, 9, 205. [Google Scholar] [CrossRef] [PubMed]
- Seidl-Seiboth, V.; Ihrmark, K.; Druzhinina, I.; Karlsson, M. Molecular Evolution of Trichoderma Chitinases. In Biotechnology and Biology of Trichoderma; Gupta, V.K., Schmoll, M., Herrera-Estrella, A., Upadhyay, R.S., Druzhinina, I., Tuohy, M.G., Eds.; Elsevier: Cambridge, MA, USA, 2014; pp. 67–78. ISBN 9780444595768. [Google Scholar]
- Carsolio, C.; Benhamou, N.; Haran, S.; Cortés, C.; Gutiérrez, A.; Chet, I.; Herrera-Estrella, A. Role of the Trichoderma harzianum Endochitinase Gene, ech42, in Mycoparasitism. Appl. Environ. Microbiol. 1999, 65, 929–935. [Google Scholar] [CrossRef] [PubMed]
- Brunner, K.; Montero, M.; Mach, R.L.; Peterbauer, C.K.; Kubicek, C.P. Expression of The ech42 (Endochitinase) Gene of Trichoderma atroviride under Carbon Starvation Is Antagonized via a BrlA-Likecis-Acting Element. FEMS Microbiol. Lett. 2003, 218, 259–264. [Google Scholar] [CrossRef] [PubMed]
- Ting, A.S.Y.; Chai, J.Y. Chitinase and β-1,3-Glucanase Activities of Trichoderma harzianum in Response towards Pathogenic and Non-Pathogenic Isolates: Early Indications of Compatibility in Consortium. Biocatal. Agric. Biotechnol. 2015, 4, 109–113. [Google Scholar] [CrossRef]
- Yoshimi, A.; Miyazawa, K.; Abe, K. Function and Biosynthesis of Cell Wall α-1,3-Glucan in Fungi. J. Fungi 2017, 3, 63. [Google Scholar] [CrossRef] [PubMed]
- Aimanianda, V.; Simenel, C.; Garnaud, C.; Clavaud, C.; Tada, R.; Barbin, L.; Mouyna, I.; Heddergott, C.; Popolo, L.; Ohya, Y.; et al. The Dual Activity Responsible for the Elongation and Branching of β-(1,3)-Glucan in the Fungal Cell Wall. MBio 2017, 8, e00619-17. [Google Scholar] [CrossRef]
- Ait-Lahsen, H.; Soler, A.; Rey, M.; de La Cruz, J.; Monte, E.; Llobell, A. An Antifungal Exo-Alpha-1,3-Glucanase (AGN13.1) from the Biocontrol Fungus Trichoderma harzianum. Appl. Environ. Microbiol. 2001, 67, 5833–5839. [Google Scholar] [CrossRef]
- Garcia-Rubio, R.; de Oliveira, H.C.; Rivera, J.; Trevijano-Contador, N. The Fungal Cell Wall: Candida, Cryptococcus, and Aspergillus Species. Front. Microbiol. 2019, 10, 2993. [Google Scholar] [CrossRef]
- Bezerra, V.H.S.; Cardoso, S.L.; Fonseca-Bazzo, Y.; Silveira, D.; Magalhães, P.O.; Souza, P.M. Protease Produced by Endophytic Fungi: A Systematic Review. Molecules 2021, 26, 7062. [Google Scholar] [CrossRef]
- Romero-Contreras, Y.J.; Ramírez-Valdespino, C.A.; Guzmán-Guzmán, P.; Macías-Segoviano, J.I.; Villagómez-Castro, J.C.; Olmedo-Monfil, V. Tal6 from Trichoderma atroviride Is a LysM Effector Involved in Mycoparasitism and Plant Association. Front. Microbiol. 2019, 10, 2231. [Google Scholar] [CrossRef] [PubMed]
- Mason, N.W.H.; de Bello, F.; Doležal, J.; Lepš, J. Niche Overlap Reveals the Effects of Competition, Disturbance and Contrasting Assembly Processes in Experimental Grassland Communities: Grassland Community Assembly Processes. J. Ecol. 2011, 99, 788–796. [Google Scholar] [CrossRef]
- Oszust, K.; Cybulska, J.; Frąc, M. How Do Trichoderma Genus Fungi Win a Nutritional Competition Battle against Soft Fruit Pathogens? A Report on Niche Overlap Nutritional Potentiates. Int. J. Mol. Sci. 2020, 21, 4235. [Google Scholar] [CrossRef] [PubMed]
- Tyśkiewicz, R.; Nowak, A.; Ozimek, E.; Jaroszuk-Ściseł, J. Trichoderma: The Current Status of Its Application in Agriculture for the Biocontrol of Fungal Phytopathogens and Stimulation of Plant Growth. Int. J. Mol. Sci. 2022, 23, 2329. [Google Scholar] [CrossRef]
- Morandi, M.A.B.; Sutton, J.C.; Maffia, L.A. Effects of Host and Microbial Factors on Development of Clonostachys rosea and Control of Botrytis cinerea in Rose. Eur. J. Plant Pathol. 2000, 106, 439–448. [Google Scholar] [CrossRef]
- Yu, J.; Wu, Y.; He, Z.; Li, M.; Zhu, K.; Gao, B. Diversity and Antifungal Activity of Endophytic Fungi Associated with Camellia oleifera. Mycobiology 2018, 46, 85–91. [Google Scholar] [CrossRef]
- Hashem, A.H.; Shehabeldine, A.M.; Abdelaziz, A.M.; Amin, B.H.; Sharaf, M.H. Antifungal Activity of Endophytic Aspergillus terreus Extract against Some Fungi Causing Mucormycosis: Ultrastructural Study. Appl. Biochem. Biotechnol. 2022, 194, 3468–3482. [Google Scholar] [CrossRef]
- Wu, S.-H.; He, J.; Li, X.-N.; Huang, R.; Song, F.; Chen, Y.-W.; Miao, C.-P. Guaiane Sesquiterpenes and Isopimarane Diterpenes from an Endophytic Fungus Xylaria sp. Phytochemistry 2014, 105, 197–204. [Google Scholar] [CrossRef]
- Shi, M.; Chen, L.; Wang, X.-W.; Zhang, T.; Zhao, P.-B.; Song, X.-Y.; Sun, C.-Y.; Chen, X.-L.; Zhou, B.-C.; Zhang, Y.-Z. Antimicrobial Peptaibols from Trichoderma pseudokoningii Induce Programmed Cell Death in Plant Fungal Pathogens. Microbiology 2012, 158, 166–175. [Google Scholar] [CrossRef] [PubMed]
- Yang, Y.; Chen, Y.; Cai, J.; Liu, X.; Huang, G. Antifungal Activity of Volatile Compounds Generated by Endophytic Fungi Sarocladium brachiariae HND5 against Fusarium oxysporum f. sp. Cubense. PLoS ONE 2021, 16, e0260747. [Google Scholar] [CrossRef] [PubMed]
- Kelemu, S.; White, J.F., Jr.; Muñoz, F.; Takayama, Y. An Endophyte of the Tropical Forage Grass Brachiaria brizantha: Isolating, Identifying, and Characterizing the Fungus, and Determining Its Antimycotic Properties. Can. J. Microbiol. 2001, 47, 55–62. [Google Scholar] [CrossRef] [PubMed]
- Gama, D.S.; Santos, Í.A.F.M.; de Abreu, L.M.; de Medeiros, F.H.V.; Duarte, W.F.; Cardoso, P.G. Endophytic Fungi from Brachiaria Grasses in Brazil and Preliminary Screening of Sclerotinia sclerotiorum Antagonists. Sci. Agric. 2020, 77, e20180210. [Google Scholar] [CrossRef]
- Mejía, L.C.; Rojas, E.I.; Maynard, Z.; Van Bael, S.; Arnold, A.E.; Hebbar, P.; Samuels, G.J.; Robbins, N.; Herre, E.A. Endophytic Fungi as Biocontrol Agents of Theobroma cacao Pathogens. Biol. Control 2008, 46, 4–14. [Google Scholar] [CrossRef]
- Bailey, B.A.; Bae, H.; Strem, M.D.; Crozier, J.; Thomas, S.E.; Samuels, G.J.; Vinyard, B.T.; Holmes, K.A. Antibiosis, Mycoparasitism, and Colonization Success for Endophytic Trichoderma Isolates with Biological Control Potential in Theobroma cacao. Biol. Control 2008, 46, 24–35. [Google Scholar] [CrossRef]
- Shittu, H.O.; Aisagbonhi, E.; Obiazikwor, O.H. Plants’ Innate Defence Mechanisms against Phytopathogens. J. Microbiol. Biotechnol. Food Sci. 2019, 9, 314–319. [Google Scholar] [CrossRef]
- Lu, H.; Wei, T.; Lou, H.; Shu, X.; Chen, Q. A Critical Review on Communication Mechanism within Plant-Endophytic Fungi Interactions to Cope with Biotic and Abiotic Stresses. J. Fungi 2021, 7, 719. [Google Scholar] [CrossRef]
- Suarez-Fernandez, M.; Marhuenda-Egea, F.C.; Lopez-Moya, F.; Arnao, M.B.; Cabrera-Escribano, F.; Nueda, M.J.; Gunsé, B.; Lopez-Llorca, L.V. Chitosan Induces Plant Hormones and Defenses in Tomato Root Exudates. Front. Plant Sci. 2020, 11, 572087. [Google Scholar] [CrossRef]
- Kappel, L.; Kosa, N.; Gruber, S. The Multilateral Efficacy of Chitosan and Trichoderma on Sugar Beet. J. Fungi 2022, 8, 137. [Google Scholar] [CrossRef]
- Shi, X.; Qin, T.; Liu, H.; Wu, M.; Li, J.; Shi, Y.; Gao, Y.; Ren, A. Endophytic Fungi Activated Similar Defense Strategies of Achnatherum sibiricum Host to Different Trophic Types of Pathogens. Front. Microbiol. 2020, 11, 1607. [Google Scholar] [CrossRef]
- Bhattacharya, A.; Sood, P.; Citovsky, V. The Roles of Plant Phenolics in Defence and Communication during Agrobacterium and Rhizobium Infection. Mol. Plant Pathol. 2010, 11, 705–719. [Google Scholar] [CrossRef] [PubMed]
- Franco-Orozco, B.; Berepiki, A.; Ruiz, O.; Gamble, L.; Griffe, L.L.; Wang, S.; Birch, P.R.J.; Kanyuka, K.; Avrova, A. A New Proteinaceous Pathogen-associated Molecular Pattern (PAMP) Identified in Ascomycete Fungi Induces Cell Death in Solanaceae. New Phytol. 2017, 214, 1657–1672. [Google Scholar] [CrossRef] [PubMed]
- Rashad, Y.; Aseel, D.; Hammad, S. Phenolic Compounds against Fungal and Viral Plant Diseases. In Plant Phenolics in Sustainable Agriculture; Lone, R., Shuab, R., Kamili, A.N., Eds.; Springer: Singapore, 2020; pp. 201–219. ISBN 9789811548895. [Google Scholar]
- Pacheco-Trejo, J.; Aquino-Torres, E.; Reyes-Santamaría, M.I.; Islas-Pelcastre, M.; Pérez-Ríos, S.R.; Madariaga-Navarrete, A.; Saucedo-García, M. Plant Defensive Responses Triggered by Trichoderma spp. as Tools to Face Stressful Conditions. Horticulturae 2022, 8, 1181. [Google Scholar] [CrossRef]
- Agostini, R.B.; Postigo, A.; Rius, S.P.; Rech, G.E.; Campos-Bermudez, V.A.; Vargas, W.A. Long-Lasting Primed State in Maize Plants: Salicylic Acid and Steroid Signaling Pathways as Key Players in the Early Activation of Immune Responses in Silks. Mol. Plant. Microbe Interact. 2019, 32, 95–106. [Google Scholar] [CrossRef]
- Ren, C.-G.; Dai, C.-C. Jasmonic Acid Is Involved in the Signaling Pathway for Fungal Endophyte-Induced Volatile Oil Accumulation of Atractylodes lancea Plantlets. BMC Plant Biol. 2012, 12, 128. [Google Scholar] [CrossRef]
- Smirnoff, N.; Arnaud, D. Hydrogen Peroxide Metabolism and Functions in Plants. New Phytol. 2018, 221, 1197–1214. [Google Scholar] [CrossRef]
- Nguyen, Q.-M.; Iswanto, A.B.B.; Son, G.H.; Kim, S.H. Recent Advances in Effector-Triggered Immunity in Plants: New Pieces in the Puzzle Create a Different Paradigm. Int. J. Mol. Sci. 2021, 22, 4709. [Google Scholar] [CrossRef]
- Ding, L.; Xu, X.; Kong, W.; Xia, X.; Zhang, S.; Liu, L.-W.; Liu, A.; Zou, L. Genome-Wide Identification and Expression Analysis of Rice NLR Genes Responsive to the Infections of Xanthomonas oryzae Pv. oryzae and Magnaporthe oryzae. Physiol. Mol. Plant Pathol. 2020, 111, 101488. [Google Scholar] [CrossRef]
- Zhang, S.; Li, C.; Si, J.; Han, Z.; Chen, D. Action Mechanisms of Effectors in Plant-Pathogen Interaction. Int. J. Mol. Sci. 2022, 23, 6758. [Google Scholar] [CrossRef] [PubMed]
- Tiwari, P.; Bae, H. Endophytic Fungi: Key Insights, Emerging Prospects, and Challenges in Natural Product Drug Discovery. Microorganisms 2022, 10, 360. [Google Scholar] [CrossRef] [PubMed]
- Adeleke, B.S.; Ayilara, M.S.; Akinola, S.A.; Babalola, O.O. Biocontrol Mechanisms of Endophytic Fungi. Egypt. J. Biol. Pest Control 2022, 32, 46. [Google Scholar] [CrossRef]
Disclaimer/Publisher’s Note: The statements, opinions and data contained in all publications are solely those of the individual author(s) and contributor(s) and not of MDPI and/or the editor(s). MDPI and/or the editor(s) disclaim responsibility for any injury to people or property resulting from any ideas, methods, instructions or products referred to in the content. |
© 2023 by the authors. Licensee MDPI, Basel, Switzerland. This article is an open access article distributed under the terms and conditions of the Creative Commons Attribution (CC BY) license (https://creativecommons.org/licenses/by/4.0/).